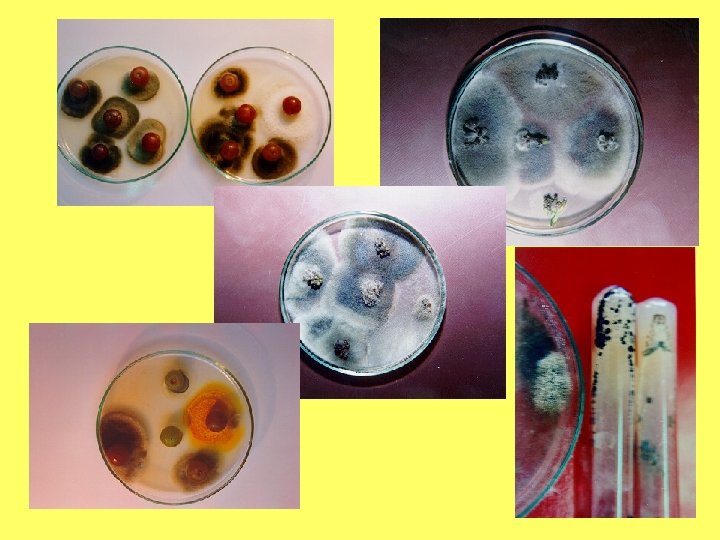
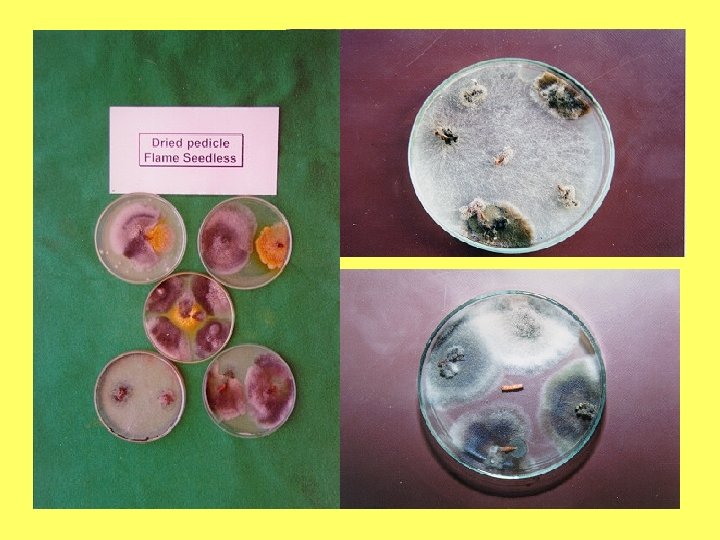

Apsergillus niger Aspergillus niger Rhizopus stolonifer Rhizopus stolonifer

- Slides: 112
Apsergillus niger
Aspergillus niger
Rhizopus stolonifer
Rhizopus stolonifer
ﻋﻔﻦ ﺍﻟﻜﻼﺩﻭﺳﺒﻮﺭﻳﻮﻡ Cladosporium rot Cladosporium spp.
ﻋﻔﻦ ﺍﻷﻠﺘﺮﻧﺎﺭﻳﺎ Alternaria rot Alternaria spp.
ﻋﻔﻦ ﺍﻟﺒﻨﻴﺴﻴﻠﻴﻮﻡ Penicillium rot Penicillium expansum Penicillium citrinum Penicillium cyclopium
Botrytis on Thompson Seedless
Botrytis on grapes at arrival
What is Botrytis? ! * Widespread fungus * Infect many crops * Grape Strawberry * Snap beans Green beans * Melons Cucumber * Stone fruits Tomato * Pome fruits Onion & Garlic
Botrytis cinerea conidiophores and conidia
Gray Mold penetration Phytopathology 85: 82 -87. 1995
Botrytis cinerea conidia germination 20 ºC 10 ºC 30 ºC
Botrytis cinerea conidia germination ótemperature dependent ólow in sterile distilled water óstimulated by pollen óstimulated by leaf or berry exudates
Botrytis cinerea sclerotia commonly found on shoots following early frost damage in the fall
Botrytis on Flame Seedless
Cultivars ﺍﻷﺼﻨﺎﻑ Flame Seedless King Ruby Crimson Thompson Early Superior Perlette
p. H
ﻧﻈﻢ ﺍﻟﺘﺪﻋﻴﻢ Trellising system • T system • Double T, Y & V system • Pergola • Gable system
Grape berry split
Grape insects (Tuber moth)
Grape insects (Tuber moth)
Grape insects (Tuber moth)
Ln (y/(1 y)) = b°+b 1 W+b 2 WT+b 3 WT 2 (Broome et al. , 1995)
Weather Station
Weather Station sensors next to the clusters
Infection vs. Temperature 70 Disease incidence, %) 60 cv. Thompson Seedless 50 40 30 20 10 0 0 5 10 15 20 Temperature, °C Dry inoculation Wet inoculation 25 30
Temperature vs Incubation, days 14 cv. Thompson Seedless 12 10 8 6 4 2 0 0 5 10 15 20 Temperature, ºC Dry inoculation Wet inoculation 25 30
Gray mold temperature vs free water
Alex 60 -69% De ser t roa d 56%
Gray Mold epidemiological model canopy Grape light nutrition Ca N K resveratrol irrigation Gray mold Micro Environ free water relative humidity inoculum source B. cinerea temper conidia
Aeration ﺗﻬﻮﻳﺔ • Canopy orientation • Leaf removal • Bunch orientation
Monitoring Botrytis on grape • • • Time of infection Density of infection Distribution of infection Proposing chemical treatment Effectiveness of applied chemicals
Time of infection Blooming Harvest Postharvest
Grape blooming
Gray Mold latent infection
Time of infection Metreological data Temperature Humidity Wetting period Humidity
Distribution of infection (Farm as a case study)
Sampling points
Botrytis cinerea RAPD-PCR, isolates from grapes (OPA 11) A. alternata A. niger Penicillium B. cinerea Plant Disease 83: 1090 -1094. 1999
Sampling time
Distribution of infection
Analysis of samples l Sampling stations s Infection % t Severity t Score (0 ->10)
Botrytis Score l l l No risk Very low risk Low risk Medium risk High risk Very high risk 0. 0 <0. 1 <1 <3 <10 >10
How to use the system for Evaluation of pesticide application
Chemical control • Use recommended fungicides. • Use approved fungicide at foreign country. • Concern fungicide resistance. • Concern harvest interval (H. I. ). • Concern residues. • Use potassium salts.
Griseofulvin on grape
Screening of 14 B. cinerea isolates for Griseofulvin production
Griseofulvin in Thompson samples
Control of Botrytis is sometimes very simple
• Time before precooling • Cool chain • Precooling defects
Postharvest SO 2 Application as Botrytis Control in Export Grapes
Gray Mold canopy management improved aeration and avoid conditions conducive to infection óleaf removal óshoot thinning óshoot positioning óhedging
Gray Mold cluster management avoid excessive cluster compactness balance clusters and foliage ócluster thinning ócluster length ó cluster density
Gray Mold nutrition ó avoid high nitrogen fertilization ó improved potassium uptake ó improved calcium content of the fruits
Gray Mold fungicide treatments Timing bloom late bloom preclosure veraison preharvest
Gray Mold postharvest control ó refrigeration, 0°C ó sulfur dioxide, SO 2 ó modified atmosphere
Postharvest Control SO 2 action ó conidia ómycelium
Postharvest Control SO 2 action óSO 2 fumigation kills surface borne spores and prevent subsequent infection of grape in the storage óLatent infections are not control with SO 2 fumigation
Postharvest Control SO 2 activity ó concentration ótime ótemperature
SO 2 time for 99% control conidia Crop Protection 11: 535 -540. 1992
SO 2 control vs concentration Crop Protection 11: 535 -540. 1992
SO 2 summary óSO 2 may be applied to grapes before cooling, during cooling or after cooling. óSO 2 toxicity depends on temperature, concentration and time. óToxicity to conidia increases about 1. 5 to 2 times/each 10 °C rise, 0°C to 20 °C.
SO 2 application time ó PRE-PACKAGING fumigation ó POST-PACKAGING SO 2 generator pads ó COLD STORAGE fumigation
SO 2 pre-packaging fumigation Objective to reduce the inoculum, conidia, present on the surface of the berries to reduced X 0
SO 2 pre-packaging fumigation when should be used it ? ó X 0 is high ó with gray mold symptoms ó disease incidence > 0. 5 -1%
SO 2 concentration: <0. 2% color varieties <0. 5% white varieties Exposure period: 15 -20 min
SO 2 post-packaging fumigation when should be used it ? ó always when transportation to markets take several days
SO 2 post-packaging fumigation Generator Pads sodium metabisulfite ó fast SO 2 release ó slow SO 2 release ó fast/slow release
SO 2 injection
SO 2 post-packaging fumigation Generator Pads Position of SO 2 pads inside the carton box
Grape boxes for exportation
SO 2 post-packaging fumigation • Advantage of using SO 2 – Killing fungal spores (Botrytis and other fungi – Keeping the green color of bunch stem and pedicles • Precautions of using SO 2 – Bleaching
Cautions for use of grapes guards 1. - Before using Grape Guards from the last season be sure that they have not been expired. 2. - Unused Grape Guards can be used the following season if they have been stored in the undamaged sealed polyethylene bags and in a dry cool area. 3. - If grapes with Dual and Slow Relese Grape Guards are allowed to warm up, excess of sulphur dioxide is released. This can damage the grapes and cause undesirable flavors, and also it increases the SO 2 residue level. 4. - The 0ºC (32ºF) refrigeration must be permanent, because the sudden increase of temperature causes damage to the fruit, and also could cause a high increment of the growth rate of the Botrytis cinerea fungi. 5. - Representative boxes of grapes must be regularly inspected while in storage, specially if it exceeds the suggested period for the utilized type of Grape Guard.
New approaches • • • Modified atmosphere Biocontrol Other Fumigants than SO 2 New fungicides Rapid detection of B. cinerea Forecasting using Metreological data